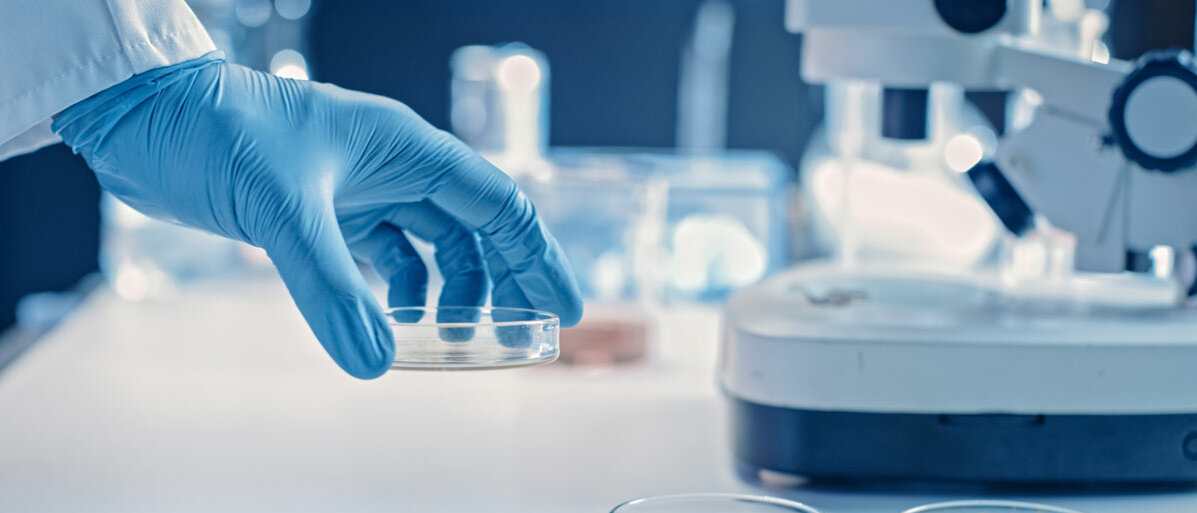

Gentechnisches Verfahren
WAS STECKT HINTER DEN MEDIKAMENTEN AUS DEM LABOR?
Seite 1/1 3 Minuten
Ein Mensch mit Diabetes "verbraucht" pro Woche etwa ein Schwein - diese Faustregel galt laut dem Bundesverband der Pharmazeutischen Industrie noch in den 80er Jahren. Damals wurden tonnenweise Schweinebauchspeicheldrüsen in Fabriken gefahren, um Insulin für Diabetiker herzustellen.
Der schwierige Herstellungsprozess war wenig ergiebig: Aus einer Tonne Schweinematerial konnten nur knapp über 100 Gramm Insulin gewonnen werden. Auch Bauchspeicheldrüsen von Rindern kamen zum Einsatz. Doch diese Zeiten sind vorbei.
Heute finden sich kein Schwein und Rind mehr in Insulin. Stattdessen wird es längst gentechnisch mit Hilfe von sogenannten Designer-Mikroorganismen hergestellt.
Dieses künstlich hergestellte Insulin ähnelt in der molekularen Struktur dem menschlichen Insulin fast bis aufs letzte Detail und ist ein Beispiel für ein weit verbreitetes Biologikum.
In der Medizin werden mittlerweile viele Arzneimittel auf diese Art und Weise hergestellt. Neben Diabetes sind etwa entzündliche Autoimmunerkrankungen wie eine rheumatoide Arthritits oder Krebsleiden Einsatzgebiete für Biologika.
Schnell wachsender Markt
In den allermeisten Fällen werden gentechnisch veränderte Bakterienstämme dazu angetrieben, Stoffe herzustellen, die körpereigenen Stoffen sehr ähneln. Aufgrund ihrer biotechnologischen Herstellung und Ähnlichkeit zu biologisch vorkommenden Stoffen nennt man sie Biologika oder auch Biologicals.
Was sich seit Mitte der 80er Jahre langsam entwickelte, ist mittlerweile einer der am schnellsten wachsenden Märkte der Pharmaindustrie. Immer mehr Biopharmazeutika finden sich in immer mehr Anwendungsgebieten in der Medizin. Mittlerweile gibt es über 270 verschiedene Wirkstoffe - auch die gegen SARS-Cov-2 eingesetzten mRNA-Impfstoffe zählen dazu.
"Biologicals bieten ein enormes Potenzial. Wir können jedes Protein des Körpers nachbauen und bei Bedarf sogar verbessern", sagt Prof.
Gerd Bendas aus der Fachgruppe Pharmazie der Rheinischen Friedrich-Wilhelms-Universität Bonn.
Großes Potenzial in der Krebsbehandlung
Der Onkologe Prof. Hans-Georg Kopp weist auf die Möglichkeiten in der Krebsbehandlung hin und sieht dort großes Potenzial für den Einsatz von Biologika. "Noch vor zehn Jahren gab es bei vielen Krebsarten kaum Angriffspunkte für eine Therapie", sagt der Chefarzt der Abteilung der molekularen und pneumologischen Onkologie am Robert-Bosch-Krankenhaus in Stuttgart. "Heutzutage haben wir bei vielen einen Ansatz."
Zwar bedeute im Falle von Tumoren therapierbar nicht auch heilbar, aber es ließen sich Lebenszeit und -qualität durch die Therapie gewinnen, erklärt Kopp und fügt an: "In den nächsten Jahren wird es für die allermeisten Tumorarten Therapieansätze geben. Es laufen derzeit so viele klinische Studien wie nie zuvor." Biologika durchlaufen dabei dieselben Studienphasen wie alle anderen Medikamente.
Bei vielen Krankheiten sind die Behandlungschancen heutzutage aufgrund der Biologicals besser. Seien es neu entwickelte Impfstoffe, symptomatische Verbesserungen bei chronischen Erkrankungen oder in der Tumortherapie. Ein Medikament so im Labor zu entwickeln, dass es präzise dort wirkt, wo es soll, ist aber eine Herausforderung. Das ist ein Grund dafür, warum Biologika noch nicht flächendeckend zur Therapie von Krankheiten zum Einsatz kommen.
Nur an der richtigen Stelle wirken
Arzneistoffe etwa, die auf dem Prinzip von zielgerichteten Antikörpern beruhen, benötigen eine klare Zielstruktur, die im Optimalfall nur auf der Zielzelle zu finden ist - und auch keiner anderen, körpereigenen Struktur ähnelt. Das heißt vereinfacht gesagt: Sie soll die kranken Zellen angreifen, aber gesunde in Ruhe lassen.
Zum Beispiel bei Rheuma. Biologika, die hier zum Einsatz kommen, sind darauf programmiert, bestimmte entzündungstreibende Signalstoffe einzufangen. Sodass die Patienten weniger Beschwerden haben. Nur: Nicht immer lässt sich eine solche Struktur isolieren. Ohne diese klare Struktur wird jeder Antikörper zu einem stumpfen Schwert und mitunter sogar schädlich für den menschlichen Körper.
Hinzu kommt, dass Biologika korrekt gehandhabt werden müssen. "Wie ein rohes Ei beim Kochen seine ursprüngliche Form verliert, so können Biologicals durch falsche Lagerung und Handhabung ihre Wirksamkei verlieren", erklärt Gerd Bendas. Bei der Anwendung wichtig zu wissen:
Biologicals werden durch Magensäure deaktiviert. Eine Einnahme als Tablette ist also nicht möglich. Das geht nur per Spritze oder Infusion.
Hohe Kosten bremsen den Einsatz
Dass sie nur dort wirken, wo sie sollen, ist nicht die einzige Problematik der Biologicals. Mitunter müssen Patienten auch ergänzende Medikamente einnehmen, die verhindern, dass der Körper sich gegen die Biologika mit Antikörpern zur Wehr setzt. Allergische Reaktionen und Unverträglichkeiten sind möglich.
Zudem sind die Entwicklungs- und Herstellungskosten vieler dieser Medikamente astronomisch hoch. Da sich für viele Krankheiten bereits gut funktionierende Behandlungen für einen Bruchteil der Kosten etabliert haben, ist es in vielen Fällen nicht wirtschaftlich, auf Biologika zurückzugreifen. "Obwohl Biologicals nur circa zwölf Prozent der auf dem Markt vorhandenen Medikamente ausmachen, machen sie knapp 31 Prozent des Umsatzes aus", sagt Bendas.
Der ökonomische Aspekt ist auch der Grund, warum Biologika oft erst dann ins Spiel kommen, wenn andere Medikamente nicht mehr helfen.
Doch Onkologe Hans-Georg Kopp glaubt, dass es auch Einsparungen geben könnte: "Wenn wir die neuen Erkenntnisse aus der Entwicklung der Biologicals nutzen, um Prävention und Prophylaxe zu verbessern, so wird unser Gesundheitssystem auf Dauer günstiger."
Quelle: dpa